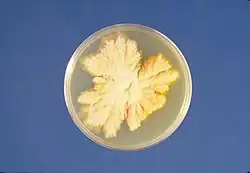
Hongos

Infección

La infección es un proceso complejo que implica la interacción de un microorganismo patógeno con un huésped susceptible. El microorganismo patógeno debe ser capaz de invadir el cuerpo del huésped, multiplicarse en él y evitar ser eliminado por el sistema inmunitario.
Las infecciones pueden deberse a bacterias, hongos, protozoos, virus, viroides y priones.[3][4] Las infecciones pueden ser además locales o sistémicas.
Término y generalidades
Infección
El científico francés Louis Pasteur demostró en 1880 que las bacterias eran la causa de muchas enfermedades, una idea que habían defendido sin éxito otros muchos científicos antes que él.[5] Al mismo tiempo, el médico alemán Robert Koch estableció las condiciones que debía cumplir una enfermedad para ser considerada infecciosa, a las que se llamó "postulados de Koch".[6]
Aunque todos los organismos pluricelulares son colonizados en algún grado por especies exteriores, la inmensa mayoría de estas habitan en una relación simbiótica o sin consecuencias para el anfitrión (comensalismo). Un ejemplo de lo anterior, son las especies de bacterias anaerobias que colonizan el colon de los mamíferos; otro ejemplo son las distintas especies de estafilococos existentes en la piel humana. Algunas características de las infecciones son el dolor, el edema y el enrojecimiento.
La infección activa es el efecto de una lucha en la cual el microorganismo infectante trata de utilizar los recursos del anfitrión para multiplicarse a su costa. El estado de la infección es, de manera frecuente, simplemente cuestión de las circunstancias. Casi todos los microorganismos, en las condiciones adecuadas, pueden volverse patógenos y casi ningún microorganismo, si está presente en pequeñas cantidades y en áreas bien protegidas por el sistema inmunitario del anfitrión, puede llevar a cabo una infección comprometedora.
Microorganismos infecciosos
Los microorganismos infecciosos son portadores de antígenos, proteínas capaces de desencadenar una respuesta inmunitaria. Los microorganismos patógenos pueden ser bacterias, hongos, protozoos o algas microscópicas. Además de estos microorganismos, existe otro grupo de agentes acelulares que no se consideran seres vivos, pero que si son microscópicos y suelen presentar una alta patogenicidad. Se trata de los virus, viroides y priones.
En general, son más conocidas las infecciones de las plantas y de los animales, aunque todos los organismos vivos pueden ser infectados.[7] Las bacterias pueden ser infectadas por virus conocidos como bacteriofagos, aunque en estos casos se suele hablar con frecuencia de parasitismo. Los virus también pueden ser infectados por otros virus más pequeños, denominados virófagos o satélites y viroides llamados virusoides.
| Principales agentes infecciosos y ejemplos: | ||||||||||||||
| ||||||||||||||
Enfermedad infecciosa
Las enfermedades infecciosas suelen clasificarse por el tipo de microorganismo que las origina, por la vía de transmisión y por sus síntomas. Más adelante se muestra una tabla con las enfermedades más frecuentes causadas por bacterias, virus, hongos y protoctistas.
Los viroides y los priones son agentes microscópicos que también tienen carácter patógeno. Los viroides son moléculas de ARN que infectan plantas y hongos que generalmente disminuyen el crecimiento del huésped. Un ejemplo de enfermedad causada por viroides es la enfermedad cadang-cadang, típica principalmente de algunas plantas cocoteras.
Los priones son proteínas con formas anómalas que pueden inducir deformaciones en las proteínas de los organismos. Están presentes en levaduras y mamíferos, en estos últimos pueden causar enfermedades como la enfermedad de Creutzfeldt-Jakob en los seres humanos o la encefalopatía espongiforme bovina o "mal de las vacas locas".
Niveles de afectación
.svg.png)
Más allá de la esfera individual de una enfermedad infecciosa, se considera que se produce una epidemia cuando se dan numerosos casos de una misma enfermedad en una comunidad o en un área geográfica reducida. Se considera que tiene lugar una pandemia cuando una enfermedad infecciosa tiene lugar en áreas geográficas muy extensas a lo largo de todo el planeta. Por último, una enfermedad infecciosa se considera endémica cuando incide de forma constante y regular en una comunidad, aunque el número de casos no sea alto. La ciencia que estudia los niveles de afectación de las enfermedades se conoce como epidemiología.
Factores
Las variables que participan en la enfermedad de un anfitrión al que se le ha inoculado un microorganismo patógeno y el resultado final son:
- La ruta de entrada del microorganismo patógeno y las zonas a las que accede.
- El período de incubación.
- La cantidad de gérmenes.
- La virulencia intrínseca del microorganismo particular.
- La toxicidad.
- El poder de invasión.
- El tiempo de actuación.
- La asociación microbiana.
- El estado inmunitario del anfitrión que está siendo colonizado.
Vías de transmisión
| Bacterias | Virus | Hongos | Protoctistas | |
|---|---|---|---|---|
| Vía respiratoria | resfriado común, gripe, sarampión, paperas | |||
| Entéricas | botulismo, salmonelosis | poliomielitis, hepatitis A | disentería amebiana | |
| Contacto directo | tétanos | rabia | micosis | |
| Vía sexual | gonorrea, sífilis | sida, herpes genital, hepatitis B | candidiasis | tricomoniasis |
| Contacto animal | peste, fiebre de las montañas rocosas | fiebre amarilla | enfermedad del sueño, malaria |
Fases de infección
Las etapas de las infecciones líticas y lisógenas pueden ser distintas que las de otros virus cuando atacan células eucariotas. Pero la mayoría de los animales muestran patrones de infección similares a la infección lítica o lisógena de las bacterias.
- Infección lítica: En una infección, un virus penetra en una célula, hace copias de sí mismo y destruye la célula. Por ejemplo el bacteriófago T4 tiene un centro de ADN dentro de una intrincada cápside de proteína que se activa al contacto con una célula. Luego inyecta su ADN directamente dentro de la célula que lo alberga, que ya no distingue entre su ADN y el ADN del virus. Por tanto comienza a producir ARN mensajero con los genes del virus. El ARNm se convierte en proteínas de virus que actúan como una cuadrilla de demolición molecular y despedazan el ADN de la célula infectada, que deja de funcionar. Luego, el virus toma el material de la célula anfitriona para hacer miles de copias de sus moléculas de ADN, con el que se arman nuevas partículas víricas. En poco tiempo, la célula infectada sufre una lisis, es decir, se rompe, y libera cientos de partículas víricas que pueden infectar a otras células. Como la célula se rompe y se destruye, el proceso se llama infección lítica.[9]
- Infección lisógena: En una infección lisógena, un virus integra su ADN en el ADN de la célula anfitriona y la información génica del virus se duplica junto a la del ADN de la célula anfitriona. A diferencia de los virus líticos, los lisógenos no destruyen de inmediato al anfitrión, sino que permanecen inactivos durante un periodo prolongado. El ADN del virus incorporado en el ADN de la célula anfitriona se llama prófago. El prófago puede formar parte del ADN de la célula anfitriona durante varias generaciones antes de activarse. Un virus quizá no permanezca indefinidamente en forma de prófago. Al final, los diversos factores pueden activar su ADN, que entonces se desprenderá del ADN de la célula anfitriona y dirigirá la síntesis de nuevas partículas víricas.[9]
Barreras, respuesta inmunitaria y profilaxis

Los seres vivos disponen de mecanismos para evitar las infecciones, en el caso de los vertebrados, los principales mecanismos son la piel y las mucosas. No obstante, algunos microorganismos consiguen adentrarse en el organismo y producir una infección, lo que hace que se desencadene una primera respuesta inmunitaria inespecífica. Al poco tiempo suele empezar a producirse una respuesta específica frente al tipo concreto de microorganismo invasor con el objetivo de eliminarlo. Para algunas infecciones, existen tratamientos médicos que ayudan a combatir la proliferación del microorganismo invasor.
Defensas externas
La primera barrera con la que cuenta el ser humano para evitar una infección es su piel, que aísla el interior de su cuerpo del exterior. Además, la piel humana tiene un ligero carácter ácido que dificulta la vida de determinadas bacterias. Otros animales se sirven además de otros mecanismos físicos como escamas o pelo. Sin embargo, los cuerpos de los vertebrados cuentan con orificios por los que podría llevarse a cabo la infección. Las mucosas constituyen también una barrera frente a la entrada de los microorganismos en cavidades con salida al exterior, y tienen un fuerte carácter ácido que impide la supervivencia de muchos de ellos; disponemos de estas mucosas en la vagina, el aparato respiratorio o el aparato digestivo. Además contamos con secreciones de sustancias químicas, como sustancias antimicrobianas, ácidos o la lisozima, presente en las lágrimas y la saliva. A estos mecanismos físicos y químicos se suman las defensas externas microbiológicas, constituidas por el microbioma, población de microorganismos que conviven con el anfitrión de forma simbiótica y dificultan la colonización de los microorganismos patógenos.[10]
Respuesta inespecífica
Una vez acontece la infección, en el organismo se desencadena una respuesta con el objetivo de combatirla. Esta primera respuesta es general e independiente del tipo de microorganismo invasor. Las células con mayor responsabilidad en esta primera respuesta inmunitaria son los leucocitos, entre los que se encuentran los neutrófilos y los monocitos maduros convertidos en macrofagos. Las células NK forman parte de esta respuesta mediante su efecto citotóxico. La principal función de los macrófagos es fagocitar a los microorganismos invasores para destruirlos y, además, presentar antígenos o fragmentos de estos a los linfocitos T (mediante el complejo principal de histocompatibilidad) para desencadenar una respuesta inmunitaria específica contra el antígeno en cuestión. El sistema del complemento, un grupo de proteínas plasmáticas, también desempeña un importante papel en esta fase, ya que se encarga de producir la lisis de los microorganismos patógenos y de unirse a su membrana para facilitar la unión a ellos de otras células inmunitarias. En esta fase de la infección tiene lugar la inflamación, que permite una mayor afluencia de leucocitos y una mayor permeabilidad de los tejidos a las células inmunitarias.
Respuesta específica
Es la respuesta que se desarrolla de forma específica ante un determinado tipo de microorganismo infeccioso. Los macrófagos que han fagocitado antígenos "presentan" estos antígenos o fragmentos de ellos a un tipo concreto de linfocito T, los linfocitos T colaboradores, que se encargan de reconocer el antígeno y de "ordenar" a los linfocitos B que produzcan anticuerpos (unas glucoproteínas también conocidas como inmunoglobulinas). Los anticuerpos facilitan la destrucción de los antígenos de forma directa (por precipitación y aglutinación) y también de forma indirecta ayudando a otras células como los neutrófilos, los macrófagos, los eosinófilos, los linfocitos T citotóxicos o los linfocitos citolíticos naturales a identificarlos y destruirlos. Otra molécula implicada en la respuesta inmunitaria es el interferón. Los linfocitos T reguladores atenúan o detienen la respuesta inmunitaria cuando el microorganismo patógeno ha sido destruido.[11]
| Principales responsables de la respuesta específica e inespecífica: | ||||||||||||
| ||||||||||||
Inmunidad natural, artificial, activa o pasiva
Se considera como inmunidad inducida artificialmente toda respuesta inmunitaria facilitada por un procedimiento médico o farmacéutico, en contraste con la inmunidad natural, que tiene lugar sin necesidad de una intervención médica (aunque puede no ser innata, como la inmunidad del feto que le proporciona el plasma materno a través de la placenta). Se considera inmunidad activa a toda aquella que requiere de la respuesta del sistema inmunitario. Un ejemplo de este tipo de inmunidad es la proporcionada por las vacunas, que todavía requiere la producción de células inmunitarias y anticuerpos por parte del organismo. Se considera inmunidad pasiva a aquella que no requiere la puesta en marcha del sistema inmunitario del organismo.[cita requerida]
| Activa | Pasiva | |
|---|---|---|
| Natural | sistema inmune | maternofetal |
| Artificial | vacuna | suero |
Antibióticos, antivirales y profilaxis
Para el control de los microorganismos se utilizan a menudo mecanismos físicos, como el aumento de la temperatura, que no son aplicables en los seres vivos. Para ello se recurre a los agentes antimicrobianos químicos de uso externo, principalmente esterilizantes como el formaldehído, desinfectantes como la lejía o antisépticos como el agua oxigenada. Muchas de las enfermedades producidas por los microorganismos se tratan con quimioterapia, que presenta una toxicidad selectiva. Según su origen, se clasifican en antibióticos (de origen natural y efectivos principalmente contra bacterias aunque también contra algunos hongos), y en sustancias quimioterapéuticas sintéticas (como el AZT) útiles contra otros tipos de microorganismos infecciosos como los virus. Además del tratamiento, una vez producida la infección, las autoridades sanitarias hacen especial hincapié en la prevención para evitar que esta se produzca.
Hipersensibilidad
El concepto de hipersensibilidad se relaciona con lo que habitualmente se conoce como alergia, fenómeno que consiste en una reacción de defensa por parte del sistema inmunitario ante un elemento no patógeno, como si este fuera un microorganismo infeccioso. Este concepto también se relaciona con el término anafilaxia.
Origen y evolución
Los microbios, en particular las bacterias y los virus fueron las primeras formas de vida y colonizan a la flora y fauna desde que estas se crearon.[12] La evolución ha resultado en una versatilidad metabólica tan grande que las bacterias pueden sobrevivir a las condiciones más adversas. Los microorganismos pueden tener vida libre, ocupar un ambiente sin relación metabólica con el anfitrión (inquilinismo), utilizar en ocasiones las fuentes energéticas del anfitrión (comensalismo y saprofitismo), asociarse al anfitrión para obtener un beneficio mutuo (simbiosis) o depender totalmente del anfitrión causando enfermedad (parasitismo).[8]
El género Homo apareció hace 3 millones de años, con la especie habilis después de un Australopithecus boisei bipedal. La evolución se asoció a un cambio del hábitat arbóreo y terráqueo al casi ilimitado que otorga el bipedalismo lo que provocó un cambió de la dieta vegetariana a la omnívora y condicionó el carácter "cazador-recolector". La organización de los homínidos durante la época del descubrimiento del fuego hace 100 000 años consistió en bandas de aproximadamente 50 individuos que eran nómadas.[8] En esos tiempos y bajo estas condiciones, las enfermedades infecciosas fueron las de sus primates antecesores, por ejemplo: infecciones con periodos de latencia prolongados, capacidad de transmisión muy elevada, relativamente benignas, asintomáticas o latentes como el herpes simple, varicela-zóster, treponematosis y la hepatitis B. Esto se planteó a raíz de un estudio en amerindios amazónicos completamente aislados de la civilización (no menos de 200 km del poblado más cercano) que no tenían conocimiento de la agricultura o el pastoreo donde se encontraron anticuerpos contra virus del herpes simple, virus de Epstein-Barr, Treponema pallidum, citomegalovirus y el virus de la hepatitis B.[13]
Estas infecciones permanecieron de esta manera hasta la agricultura y la domesticación de los animales (12 o 13 mil años) donde aparecieron las zoonosis. Con los perros, los humanos adquirieron la rabia y el sarampión; los gatos propiciaron la aparición de toxoplasmosis; los caballos, el muermo y los rinovirus; las cabras, la brucelosis; los cerdos, las teniosis, salmonelosis y gripe; los bovinos, la tuberculosis, la teniasis y la difteria; del búfalo de agua, la lepra; y de los pericos, la ornitosis.[14] No obstante, existen claras diferencias entre las infecciones en estos animales y en el hombre.
| Grupo | Contagiosidad | Morbilidad | Mortalidad | Formas subclínicas | Formas crónicas | Portadores | Reservorios animales |
|---|---|---|---|---|---|---|---|
| Específicas del hombre[n. 1] (antroponosis) | +++/++++ | ++++ | 0/+ | ++++ | 0/+ | +++ | 0 |
| Zoonosis[n. 2] | +/+++ | +++ | +/+++ | ++ | +/++ | 0/+ | ++++ |
| Varias formas de transmisión[n. 3] | 0/+ | + | ++/+++ | 0 | 0 | 0 | 0/+ |
| |||||||
| Nota: La clasificación es arbitraria y va de 0 a ++++. | |||||||
| Científicos de importancia histórica en el estudio de las infecciones: | ||||||||||||||
| ||||||||||||||
Ejemplos y casuística
A modo de ejemplo, las especies de estafilococos presentes en la piel se mantienen inofensivas, pero cuando se introducen en un espacio normalmente estéril, como es la cápsula de una articulación o el peritoneo, se multiplican sin resistencia y crean una gran carga para el anfitrión.Una infección cruzada es la transmisión de microorganismos infecciosos entre los pacientes y el personal en un entorno clínico. La transmisión puede ser el resultado del contacto directo, persona a persona o indirecto mediante objetos contaminados que se denominan “fomites”.[15]
Véase también
- bacteria
- bacteria patógena
- enfermedad infecciosa
- infectología
- inmunología
- microbiología
- microbios o microorganismos
- profilaxis
- quimioterapia
- sistema inmune
- virus
Notas y referencias
- ↑ "The History of the Germ Theory," 'The British Medical Journal' vol. 1 no. 1415 (1888), p. 312.
- ↑ Madigan M, Martinko J (editors). (2005). Brock Biology of Microorganisms (11th ed. ed.). Prentice Hall. ISBN 0-13-144329-1.
- ↑ Dr. Jorge Antonio Amézquita Landeros, Dr. José Luis Jiménez Corona (29-ago-2011). «Capítulo8: Infección en cirugía». En Dr. Jesús Tápia Jurado; Dr.Abel Archundia García; Dr. Wulfrano Antonio Reyes Arellano, eds. Introducción a la cirugía. México: McGraw-Hill (publicado el 20-sep-2011). pp. 119-134. ISBN 978-607-02-2469-0.
- ↑ Término MeSH: Infection.
- ↑ Pasteur ML. De l'extension de la théorie des germenes à l'étiologie de quelques maladies communes. Comptes rendus de l'Académie des sciences 1880, t. 90.
- ↑ Biología, 2o bachillerato. Editorial ECIR. VVAA. ISBN 84-7065-820-4
- ↑ Proyecto La Casa del Saber. Biología, 2 Bachillerato. Editorial Santillana. VVAA. ISBN 8429409793
- ↑ a b c d e Kumate, Jesús; Gutiérrez, Gonzalo; Muñoz, Onofre; Santos, Ignacio; Solórzano Fontino; Miranda Guadalupe (2008). «Capítulo 1: Origen y evolución de las enfermedades infecciosas». Infectología Clínica Kumate-Gutiérrez (17.ª edición). México: Méndez Editores (publicado el 2009). pp. 3-11. ISBN 968-5328-77-3. OCLC 728653050.
- ↑ a b Miller, Kenneth (2004). «19». Biología. Massachusetts: Prentice Hall. pp. p.480. ISBN 0-13-115538-5.
- ↑ Biología, Pruebas de acceso a la universidad. Selectividad 2012. Editorial Anaya. VVAA. ISBN 978-84-678-3569-4
- ↑ Biología, Pruebas de acceso a la universidad. Selectividad 2013. Editorial Anaya. VVAA. ISBN 978-84-678-4510-5
- ↑ Viral evolution: Primordial cellular origins and late adaptation to parasitism. NCBI.
- ↑ Black, F.L. (14 de febrero de 1975). «Infectious diseases in primitive societies.» [Enfermedades infecciosas en las sociedades primitivas]. Science (4176): 515-8. PMID 163483. doi:10.1126/science.163483. Consultado el 31 de marzo de 2012. (requiere suscripción).
- ↑ Cockburn, T.A. (1977). «Where did our infections diseases arise?». Health and Disease in Tribal Societies. Amsterdam: Elsevier:Ciba foundation. p. 103.
- ↑ Delpiano, Miguel. Infecciones Cruzadas en las Prácticas de Salud Ambulatorias. Pág. 19. Medwave. 2009